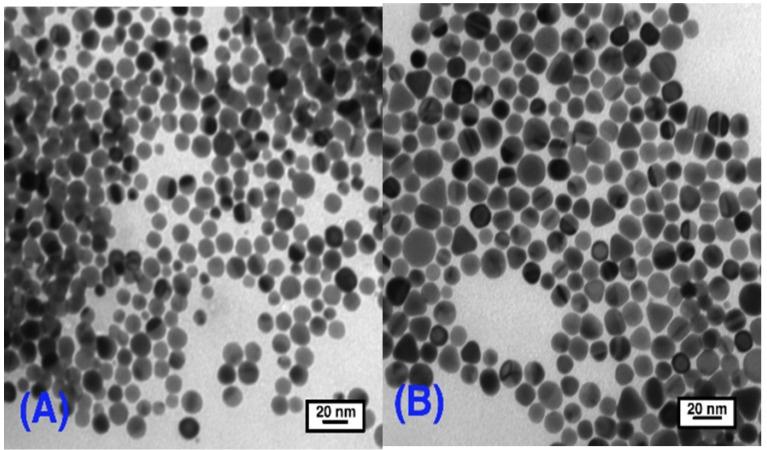
https://cdn.ncbi.nlm.nih.gov/pmc/blobs/71e9/5304655/816caeeb1c01/nanomaterials-03-00370-g006.jpg

烷基和芳香胺作为金纳米颗粒的消化成熟/尺寸聚焦剂
Alkyl and Aromatic Amines as Digestive Ripening/Size Focusing Agents for Gold Nanoparticles.
作者信息
Sun Yijun, Jose Deepa, Sorensen Christopher, Klabunde Kenneth J
机构信息
Department of Chemistry, Kansas State University, Manhattan, KS 66506, USA.
Department of Physics, Kansas State University, Manhattan, KS 66506, USA.
出版信息
Nanomaterials (Basel). 2013 Jul 5;3(3):370-392. doi: 10.3390/nano3030370.
Both long chain alkyl thiols and alkyl amines behave as size focusing agents for gold nanoparticles, a process that is under thermodynamic control. However, amines do not oxidize surface gold atoms while thiols do oxidize surface gold to gold(I) with evolution of hydrogen gas. Therefore, alkyl amines participate in digestive ripening by a different mechanism. The efficiency of alkyl amines for this process is described and compared, and ultimate gold particle size differences are discussed. Reported herein is a detailed investigation of alkyl chain lengths for alkyl amines, aromatic amines (aniline), and unusually reactive amines (2-phenylethyl amine). Also, two methods of preparation of the crude gold nanoparticles were employed: gold ion reduction/inverse micelle metal vaporization (Solvated Metal Atom Dispersion-SMAD).
长链烷基硫醇和烷基胺都可作为金纳米颗粒的尺寸聚焦剂,这一过程受热力学控制。然而,胺类不会氧化表面金原子,而硫醇会将表面金氧化为金(I)并释放出氢气。因此,烷基胺通过不同的机制参与消化熟化过程。本文描述并比较了烷基胺在该过程中的效率,并讨论了最终金颗粒尺寸的差异。本文详细研究了烷基胺、芳香胺(苯胺)和异常活泼的胺(2-苯乙胺)的烷基链长度。此外,还采用了两种制备粗金纳米颗粒的方法:金离子还原/反胶束金属汽化(溶剂化金属原子分散法-SMAD)。